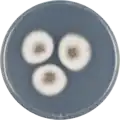
Aspergillus venezuelensis growing on CYA plate

Aspergillus venezuelensis
| Aspergillus venezuelensis | |
|---|---|
| Scientific classification | |
| Kingdom: | Fungi |
| Division: | Ascomycota |
| Class: | Eurotiomycetes |
| Order: | Eurotiales |
| Family: | Aspergillaceae |
| Genus: | Aspergillus |
| Species: | A. venezuelensis
|
| Binomial name | |
| Aspergillus venezuelensis Frisvad & Samson (2004)[1]
| |
Aspergillus venezuelensis is a species of fungus in the genus Aspergillus. It is from the Nidulantes section.[2] The species was first described in 2004.[1] It has been shown to produce aflatoxin B1 and sterigmatocystin.[1]
In 2016, the genome of A. venezuelensis was sequenced as a part of the Aspergillus whole-genome sequencing project - a project dedicated to performing whole-genome sequencing of all members of the genus Aspergillus.[3] The genome assembly size was 34.84 Mbp.[3]
Growth and morphology
Aspergillus venezuelensis has been cultivated on both Czapek yeast extract agar (CYA) plates and Malt Extract Agar Oxoid (MEAOX) plates. The growth morphology of the colonies can be seen in the pictures below.
-
Aspergillus venezuelensis growing on CYA plate
Aspergillus venezuelensis growing on CYA plate -
 Aspergillus venezuelensis growing on MEAOX plate
Aspergillus venezuelensis growing on MEAOX plate
References
- ^ a b c Frisvad, J.C.; Samson, R.A. 2004. Emericella venezuelensis, a new species with stellate ascospores producing sterigmatocystin and aflatoxin B1. Systematic and Applied Microbiology. 27:672-680
- ^ Chen, A.J.; Frisvad, J.C.; Sun, B.D.; Varga, S.; Kocsubé, S.; Dijksterhuis, J.; Kim, D.H.; Hong, S.-B.; Houbraken, J.; Samson, R.A. (2016). "Aspergillus section Nidulantes (formerly Emericella): Polyphasic taxonomy, chemistry and biology". Studies in Mycology. 84: 1–118. doi:10.1016/j.simyco.2016.10.001. PMC 5198626. PMID 28050053.
- ^ a b "Home - Aspergillus venezuelensis CBS 868.97 v1.0". Mycocosm.jgi.doe.gov. Retrieved 2 May 2022.